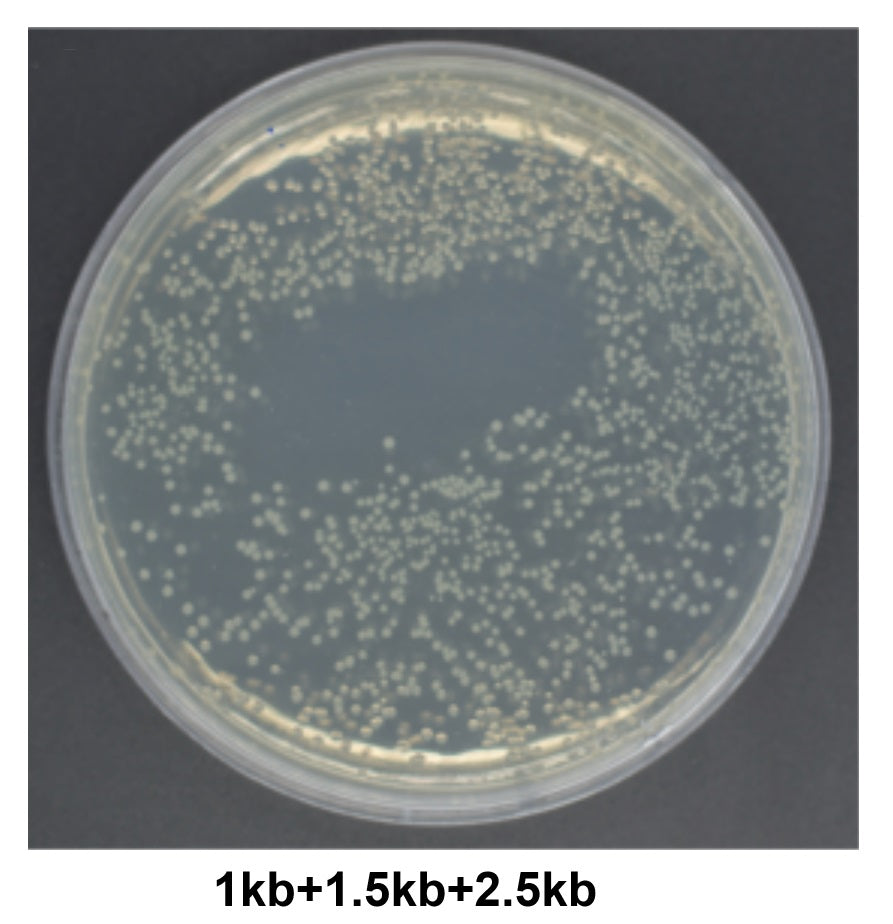

Catégories de produits
-
-
-
- Guide de sélection des enzymes (26)
- ADN polymérase (18)
- ARN polymérase (5)
- Transcriptase inversée (4)
- ADN / ARN ligase (6)
- Nucléase (26)
- Enzyme de modification (19)
- Enzymes de restriction (32)
- Inhibiteur de la RNASE (4)
- Enzyme d'édition de gènes (4)
- Transposase (0)
- Protéase (15)
- Glycosidase (7)
- Autres enzymes (1)
- Enzyme multifonctionnelle (0)
- Enzyme de coiffage (3)
- Phosphatase (2)
- Molécules bioactives (15)
- Antibiotiques (19)
Promotion
21 produits
Affichage 1 - 21 de 21 produits
Nous apprécions sincèrement le soutien et la confiance de nos précieux clients. Pour témoigner notre gratitude, nous présenterons chaque mois des produits promotionnels sur ce site Web. Veuillez noter que ces promotions sont exclusivement disponibles aux États-Unis. Pour les clients situés hors des États-Unis, nous vous recommandons de contacter vos distributeurs locaux pour obtenir des informations sur les offres promotionnelles. Merci de votre compréhension et de votre soutien.
Des échantillons gratuits sont disponibles pour tous les produits répertoriés sur cette page pour les clients américains.
Affichage 1 - 21 de 21 produits
Afficher
Voir
Sauvegarder $60.00

Yeasen
Kit de synthèse d'ARN à haut rendement -10623es
Prix de venteDepuis $165.00
Prix régulier$225.00
Sauvegarder $100.00


Yeasen
Réactif de transfection Hieff Trans ™ PEI -40820ES
Prix de venteDepuis $125.00
Prix régulier$225.00
Sauvegarder $20.00

Yeasen
Polyéthylèneimine linéaire (PEI) MW40000, lyse rapide -40816ES
Prix de venteDepuis $185.00
Prix régulier$205.00
Sauvegarder $20.00


Yeasen
Hieff Unicon ™ Universal Blue QPCR Master Mix _ 11184ES
Prix de venteDepuis $35.00
Prix régulier$55.00


Yeasen
HIFAIR ™ AdvanceFast 1st Strand ADNc Synthesis Supermix pour qPCR (GDNA Digester Plus) _ 11155ES
Prix de venteDepuis $55.00
Sauvegarder $135.00


Yeasen
Mycaway ™ Plus-Color Kit de détection MyCoplasma en une couleur -40612ES
Prix de venteDepuis $100.00
Prix régulier$235.00


Yeasen
2 × Hieff ™ Hotstart PCR Genotyping Master Mix (avec colorant) _ 10108ES
Prix de venteDepuis $20.00


Yeasen
2 × Hieff Canace ™ AdvanceFast High-Fidelity PCR Master Mix (avec colorant) -10164ES
Prix de venteDepuis $20.00
Sauvegarder $10.00


Yeasen
2 × Hieff ™ Ultra-Rapid II Hotstart Universal PCR Master Mix _ 10167ES
Prix de venteDepuis $30.00
Prix régulier$40.00
Sauvegarder $86.00


Yeasen
Matrice Ceturegel ™ pour la culture organoïde, phénol sans rouge, sans LDEV _ 40191ES
Prix de venteDepuis $129.00
Prix régulier$215.00
Sauvegarder $70.00

Yeasen
Protéine A / G MAGBEADS (grade IP) -36417ES
Prix de venteDepuis $105.00
Prix régulier$175.00
Sauvegarder $195.00

Yeasen
Gel d'affinité anti-dykdddddk (drapeau) -20584E
Prix de venteDepuis $190.00
Prix régulier$385.00


Yeasen
Coloration de gel acide nucléique annuel (10 000 × dans l'eau) -10202E
Prix de venteDepuis $15.00
Filtres (0)